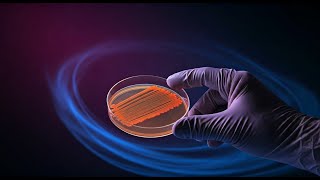

Anshu Singh
I am a University and College Professor who teaches Biology, Anatomy & Physiology and Microbiology. I am a Microbiologist who loves to view microbes under the microscope. Anything in Nature excites me. I love cooking, gardening, dancing, travelling, and teaching, of course.
Shared 2 months ago
30 views
Shared 3 months ago
38 views
Shared 4 months ago
27 views
Shared 8 months ago
31 views
Shared 8 months ago
12 views
Shared 9 months ago
33 views
Shared 9 months ago
32 views
Shared 11 months ago
32 views
Shared 11 months ago
39 views
Shared 1 year ago
54 views
Shared 1 year ago
22 views
Shared 1 year ago
47 views
Shared 1 year ago
70 views
Shared 1 year ago
84 views
Shared 1 year ago
46 views